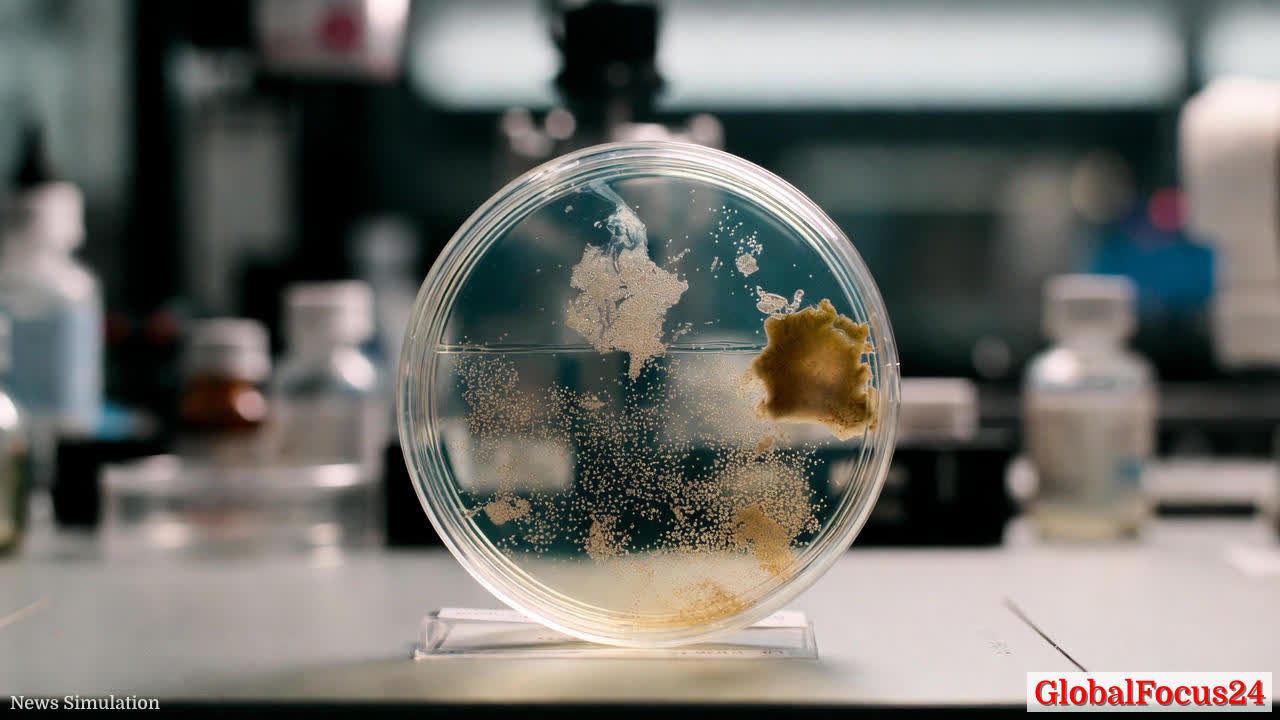

Moss in Space: Nine-Month Survival Sparks Fresh Look at Space Agriculture
A recent study reveals that moss spores from Physcomitrium patens survived nine months outside the International Space Station and later germinated on Earth at an impressive rate. After the spores were returned, 86 percent successfully germinated and began growth, marking a notable milestone in the growing body of space biology research. The findings, presented by researchers who tested the spores under simulated space conditions and then in real space exposure, underscore both the resilience of certain plant life forms and the potential implications for sustainable human presence beyond Earth.
Historical context: resilience in dormancy as a pathway to space exploration Botanical resilience has long fascinated scientists seeking to understand lifeās adaptability to harsh environments. Mosses, among the earliest land plants, occupy a niche that emphasizes resilience through desiccation tolerance and dormancy. In the context of space exploration, these traits gain new significance. Dormant spores and seeds can endure prolonged periods of low water activity, intense radiation, and temperature fluctuationsāconditions that are commonplace in outer space. The moss study adds to a thread of historical experiments testing plant survivability outside Earthās atmosphere, tracing a lineage from early seed exposures to modern, mission-parameterized assessments.
Experimental approach and interpretation The studyās methodology began with controlled simulations: spores endured vacuum, ultraviolet radiation, and temperature extremes to gauge each stressorās individual and combined effects. The researchers then subjected actual spores to space exposure via a tour on the International Space Station. Upon return to Earth, germination rates provided a tangible readout of viability after months of cosmic exposure. The central resultā86 percent germinationāspeaks to a robust tolerance in the dormant state and reinforces the idea that certain plant life forms can endure, and potentially thrive, after spaceflight experiences that would be lethal to more metabolically active organisms.
Scientific implications for space agriculture and life-support systems The practical implications of moss spore durability extend into the design of life-support systems and bioregenerative life support concepts (BLSS) for long-duration missions. If dormant plant forms can be safely stored, transported, and later germinated on-site, this could reduce the need to launch fully grown plants and the resources tied to their cultivation. Dormancy-tolerant crops could serve as a foundational element for oxygen production, carbon balance, and nutrient recycling in closed environments aboard spacecraft or future space stations. The study also prompts a careful look at how hydrated versus dormant states influence radiation sensitivity and DNA repair pathways, which in turn informs selection criteria for plant species used in extraterrestrial settings.
Regional and economic considerations: space programs, logistics, and regional capabilities Across spacefaring nations, research on plant resilience in space dovetails with broader strategies for economic resilience and technological leadership. Nations with robust biosciences and space agencies can leverage findings like these to bolster domestic partnerships between universities, research centers, and industry players focused on space agriculture, bioprocessing, and space infrastructureāareas expected to attract investment as space missions extend beyond the current footprint. The ability to deploy hardy, dormancy-ready plant material could reduce logistical complexity for missions, particularly those targeting lunar bases or Mars habitats where resupply windows are limited and timing is critical.
Comparative perspectives: how moss spores compare with other space survivors Historically, a variety of organisms have demonstrated space endurance, including bacteria, lichens, seeds, and tardigrades. Earlier experiments showed mixed outcomesāsome surviving multi-month exposures, others suffering significant damage or reduced fertility. The moss sporesā high germination rate after nine months adds a favorable data point to this spectrum. The broader takeaway is that dormancy, protective barriers such as the sporangium, and the inherent stress tolerance of certain life forms collectively influence survivability. Comparing moss spores with hydrated, metabolically active material reveals a fundamental truth: the state of the organism at exposure dramatically shapes outcomes. Dormant forms tend to weather space conditions more effectively than actively growing tissue.
Biological mechanisms at play: why dormancy matters In the reported experiments, the sporesā dried, dormant state is a key factor in resilience. Dehydration minimizes metabolic activity, reducing the risk of radiation-induced reactive oxygen species and other damage pathways. The sporangium acts as a natural shield, offering additional protection against radiation and environmental stress. Though dormant, these spores still carry genetic material that ultimately needs repair once rehydrated. The next research phase focuses on assessing DNA damage incurred during space exposure and mapping the plantās repair mechanisms as germination proceeds. Understanding these processes can guide genetic and agronomic strategies to enhance space-compatible crops.
Potential implications for long-duration missions and planetary habitats If dormant plant material can be stored and reactivated after extended spaceflight, mission planners gain a practical tool for sustaining crew life in deep-space habitats. In-situ agriculture, supported by hardy plant species, could provide fresh food, oxygen regeneration, and psychological benefits from growing living ecosystems within sealed environments. The concept of constructing greenhouses on the Moon or Marsācomplemented by terrestrial seed banks that maintain dormancy-ready stockāaligns with longer-term plans for off-Earth colonization. However, researchers caution that translating dormant-spore success to hydrated, actively growing plants remains a challenge, underscoring the need for phased, rigorous testing before any large-scale deployment.
DNA repair and future research directions The immediate research question centers on post-flight DNA integrity and the resilience of repair pathways in Physcomitrium patens. DNA damage from multi-source radiation, combined with vacuum and extreme temperatures, could have lasting effects on growth, reproduction, and adaptation. Investigators will seek to quantify the extent of genetic lesions, identify repair gene expression patterns, and determine whether subsequent generations can fully recover normal function. Comparative studies with other moss species, seeds, and hardy gymnosperms may reveal conserved strategies or species-specific differences that inform plant selection for space-based cultivation systems.
Historical echoes: lessons from longer past experiments From the late 2000s onward, space biology programs have conducted multi-generational seed exposures to test fertility and germination under stress. In some cases, seeds survived extended exposure but exhibited impaired growth or reduced reproductive capacity in subsequent generations. These outcomes emphasize that survival does not always equate to sustained vitality, and that downstream generational effects warrant careful monitoring. The moss sporesā strong germination rate after nine months suggests that dormant states may bypass some of the growth defects seen in hydrated, active tissue exposed to space conditions, but this remains a critical area for ongoing study.
Public interest and perception: science advancing public understanding News of resilient spores has the potential to captivate public imagination, highlighting how basic biology intersects with space exploration. Demonstrations of plant survivability in extreme environments can serve as powerful storytelling anchors for science education, inspiring curiosity about space agriculture, life-support systems, and the delicate balance between biology and engineering required to sustain human life beyond Earth. Public reaction often reflects a mix of wonder and practical optimism: if plants can endure space conditions, human exploration and settlement become incrementally more feasible.
Economic landscape: investment and collaboration opportunities The research intersects with growing private-public collaborations in space infrastructure, biomanufacturing, and off-Earth agriculture. Technology transfer opportunities could include system designs for autonomous greenhouse modules, robotic farming tools, and resilient seed banks tailored for space environments. As space agencies and commercial ventures chart routes to the Moon, Mars, and deep-space habitats, supported by international partnerships, the economic incentives to invest in hardy, dormancy-based plant systems are likely to strengthen.
Conclusion: a stepping stone toward practical space agriculture The nine-month survival and subsequent high germination rate of Physcomitrium patens spores in space illuminate a path forward for space agriculture that balances scientific curiosity with practical application. While daylight on hydrated, actively growing plant material in space remains a more complex challenge, the resilience demonstrated by dormant spores validates a core premise: life can endure, and potentially thrive, in environments far beyond Earthās atmosphere when built upon robust biological strategies and protective mechanisms. As researchers continue to map DNA repair dynamics and life-support capabilities, the broader scientific and economic communities will watch closely for how these findings translate into scalable, real-world solutions for sustaining human presence in space.